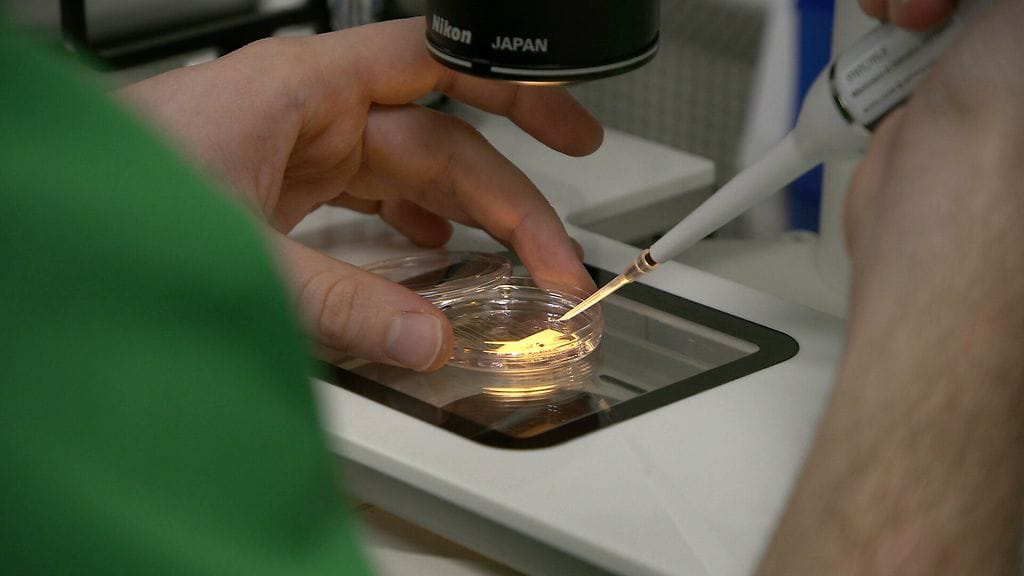
Munasolut Mehiläinen Felicitas laboratorio

Suomessa pakastetaan munasoluja myöhempää käyttöä varten vain harvoin. Selvitimme, mistä toimenpiteessä on kyse.
Korona-ajan vauvabuumi jäi lyhyeksi, eikä synnytystalkoisiin patistaminen ole ottanut tuulta alleen. Lapsia syntyi viime vuonna ennätyksellisen vähän, ja lasku jatkui myös alkuvuonna 2023. Samalla lastenhankintaa lykätään niin, että viime vuonna ensisynnyttäjien ikä oli jo keskimäärin 30,1 vuotta.
Syitä lykkäämiselle voi olla lapsettomuusklinikka Felicitas Mehiläisen naistentautien ja synnytysten erikoislääkäri Liisa Häkkisen mukaan esimerkiksi epävarma työtilanne tai sopivan kumppanin puute, mutta naisten ja muiden synnyttävien harmiksi biologinen kello ei näitä syitä ymmärrä. Suomessa on noin kymmenen vuoden ajan voinut ostaa lastenhankinnalle hieman lisäaikaa munasolujen ennakoivalla pakastamisella, mutta toistaiseksi hoidon suosio on ollut vielä varsin vähäistä.
Mistä tässä tuhansia euroja maksavassa toimenpiteessä on kyse? Selvitimme vastaukset yleisimpiin kysymyksiin.
Lue myös: Jasmine, 35, osti lisäaikaa lastenhankintaan – näin toimii munasolujen pakastaminen
1. Mikä on yleisin syy munasolujen pakastamiselle?
Munasolujen pakastamisella halutaan parantaa raskaaksi tulemisen mahdollisuuksia myöhemmässä vaiheessa elämää. Syitä munasolujen pakastamiseen on useita, mutta yleisimpiä syitä ovat esimerkiksi koulunkäynnin ja työuran jatkaminen tai sopivan kumppanin puute. Häkkinen kertoo, että hänen vastaanotollaan näkyy nykyisin myös yleinen epävarmuus maailmantilanteesta syynä lykätä perheen perustamista.